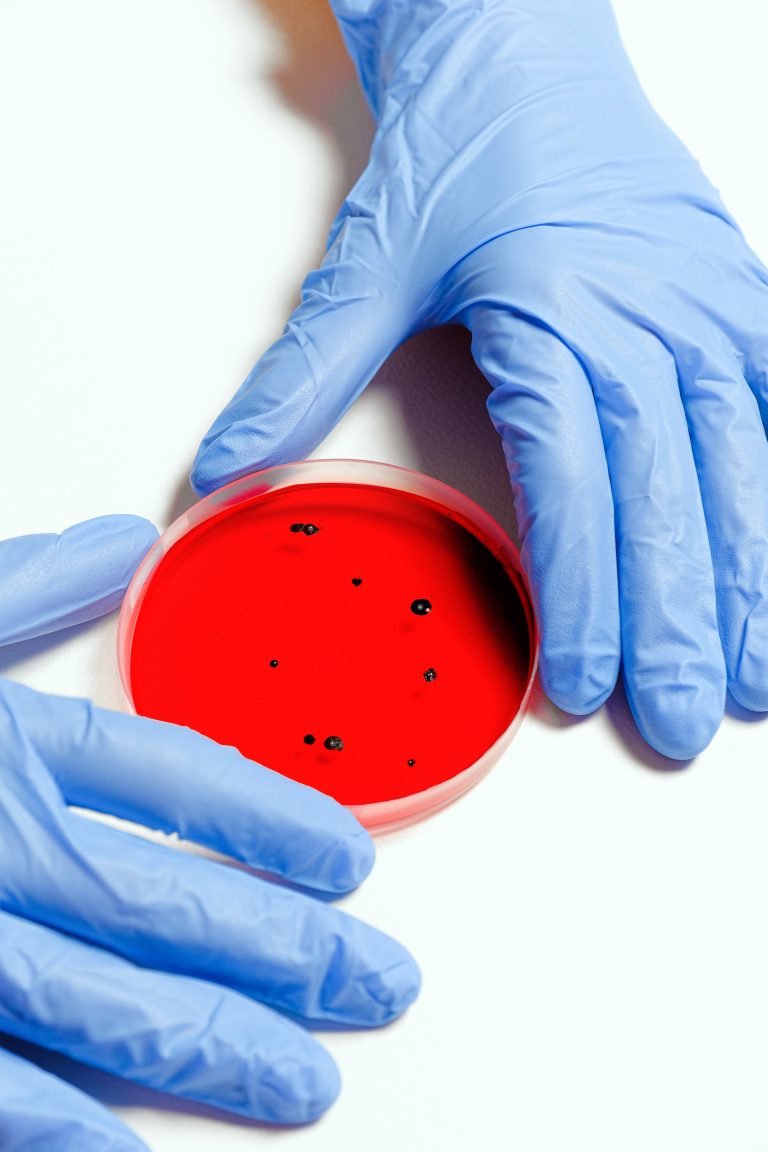
Leia mais sobre o artigo O congelamento mata bactérias?

Os aparelhos dentários são indicados no tratamento de alinhamento dos dentes, a fim de melhorar a funcionalidade (mastigação e mordida), além de contribuir para a melhora da aparência estética. Confira…
O AVC – Acidente Vascular Cerebral, é uma enfermidade que pode acometer qualquer um de nós, principalmente se não cuidarmos da nossa saúde e da nossa alimentação corretamente para evitar o AVC.…
Cerca de 50% da população mundial precisará da ajuda de equipamentos de visão até 2050. No entanto, muitos ainda desconhecem os benefícios da lente de contato e, por isso, acabam…

Anatomy of the male reproductive system. Digital illustration.
Remédio para aumentar o pênis estão entre os mais procurados pelos homens, mas como eles funcionam? É confiável, realmente aumentam o órgão masculino? Vamos abordar algumas opções disponíveis hoje em…
Hoje, essas Manchas de Espinhas podem ser eliminadas através de diferentes técnicas e tratamentos. É importante que as pessoas evitem tocar as espinhas no rosto para não adquirir essas marcas indesejáveis. Existem dois tipos de cicatrizes…
Você sabe como melhorar o sistema imune? Seu sistema imunológico tem uma grande tarefa. Ele combate os germes e impede que você sucumba a doenças e enfermidades. Como seu sistema…
A dor de dente ocorre quando há algo errado prejudicando a sua boca, que pode ser desde um dente podre, uma simples cárie ou até mesmo uma infecção, causando sensibilidade,…
Dezenas de estudos que remontam várias décadas associam a massagem a benefícios físicos e psicológicos reais. Inclusive, um estudo australiano descobriu que uma massagem muscular pós-treino de 10 minutos pode…
Para o funcionamento adequado do setor industrial é preciso ter atenção a uma série de questões, principalmente no que se trata da relação entre os funcionários e o seu local…
Cuidar da saúde mental é algo fundamental para que o indivíduo se sinta preparado para encarar qualquer que sejam os desafios do dia a dia. Seja em sua vida pessoal…
A telemedicina funciona como um aplicativo de marcação de consultas, você marca um atendimento médico via telemedicina sem sair de casa e ajuda a desafogar o sistema de saúde. O…
Descubra se você pode estar causando um mal à sua saúde sem saber. Muitas pessoas falam sobre o congelamento de alimentos para acabar com as bactérias presentes neles. Seja carne,…